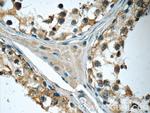
IFT122 Antibody in Immunohistochemistry (Paraffin) (IHC (P))
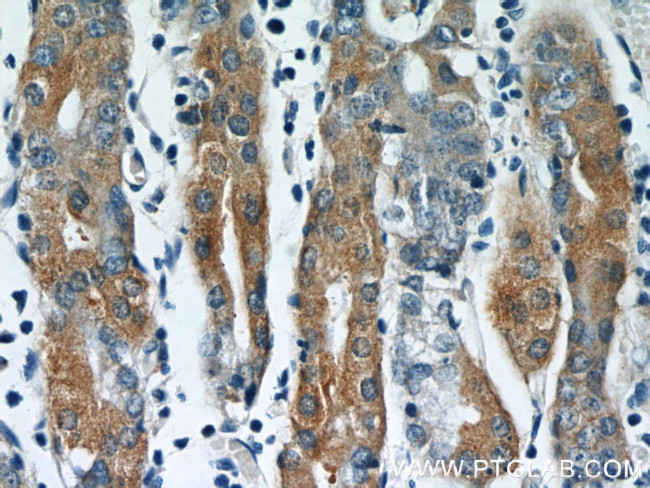
IFT122 Antibody in Immunohistochemistry (Paraffin) (IHC (P))

Search
Proteintech
IFT122 Polyclonal Antibody
{{$productOrderCtrl.translations['antibody.pdp.commerceCard.promotion.promotions']}}
{{$productOrderCtrl.translations['antibody.pdp.commerceCard.promotion.viewpromo']}}
{{$productOrderCtrl.translations['antibody.pdp.commerceCard.promotion.promocode']}}: {{promo.promoCode}} {{promo.promoTitle}} {{promo.promoDescription}}. {{$productOrderCtrl.translations['antibody.pdp.commerceCard.promotion.learnmore']}}

Please note: We are reviewing Western blot images included in the antibody testing data in our catalog, including those provided by third parties. Unless expressly labeled or annotated as “raw-unedited”, Western blot images included in the antibody testing data in our catalog may have been edited, optimized or otherwise adjusted for presentation.
产品信息
19304-1-AP
种属反应
已发表种属
宿主/亚型
分类
类型
抗原
偶联物
形式
浓度
规格
纯化类型
保存液
内含物
保存条件
运输条件
产品详细信息
Immunogen sequence: MRAVLTWRD KAEHCINDIA FKPDGTQLIL AAGSRLLVYD TSDGTLLQPL KGHKDTVYCV AYAKDGLWSP EQKSVSKHKS SSKIICCSWT NDGQYLALGM FNGIISIRNK NGEEKVKIER PGGSLSPIWS ICWNPSREER NDILAVADWG QKVSFYQLSG KQIGKDRALN FDPCCISYFT KGEYILLGGS DKQVSLFTKD GVRLGTVGEQ NSWVWTCQAK PDSNYVVVGC QDGTISFYQL IFSTVHGLYK DRYAYRDSMT DVIVQHLITE QKVRIKCKEL VKKIAIYRNR LAIQLPEKIL IYELYSEDLS DMHYRVKEKI IKKFECNLLV VCANHIILCQ EKRLQCLSFS GVKEREWQME (1-359 aa encoded by BC004238)
靶标信息
This gene encodes a member of the WD repeat protein family. WD repeats are minimally conserved regions of approximately 40 amino acids typically bracketed by gly-his and trp-asp (GH-WD), which may facilitate formation of heterotrimeric or multiprotein complexes. Members of this family are involved in a variety of cellular processes, including cell cycle progression, signal transduction, apoptosis, and gene regulation. This cytoplasmic protein contains seven WD repeats and an AF-2 domain which function by recruiting coregulatory molecules and in transcriptional activation. Alternate transcriptional splice variants, encoding different isoforms, have been characterized.
仅用于科研。不用于诊断过程。未经明确授权不得转售。
生物信息学
蛋白别名: intraflagellar transport 122 homolog; Intraflagellar transport protein 122 homolog; WD repeat domain 10; WD repeat-containing protein 10; WD repeat-containing protein 140
基因别名: C86139; IFT122; sopb; SPG; WDR10; WDR140
UniProt ID: (Mouse) Q6NWV3
Entrez Gene ID: (Mouse) 81896